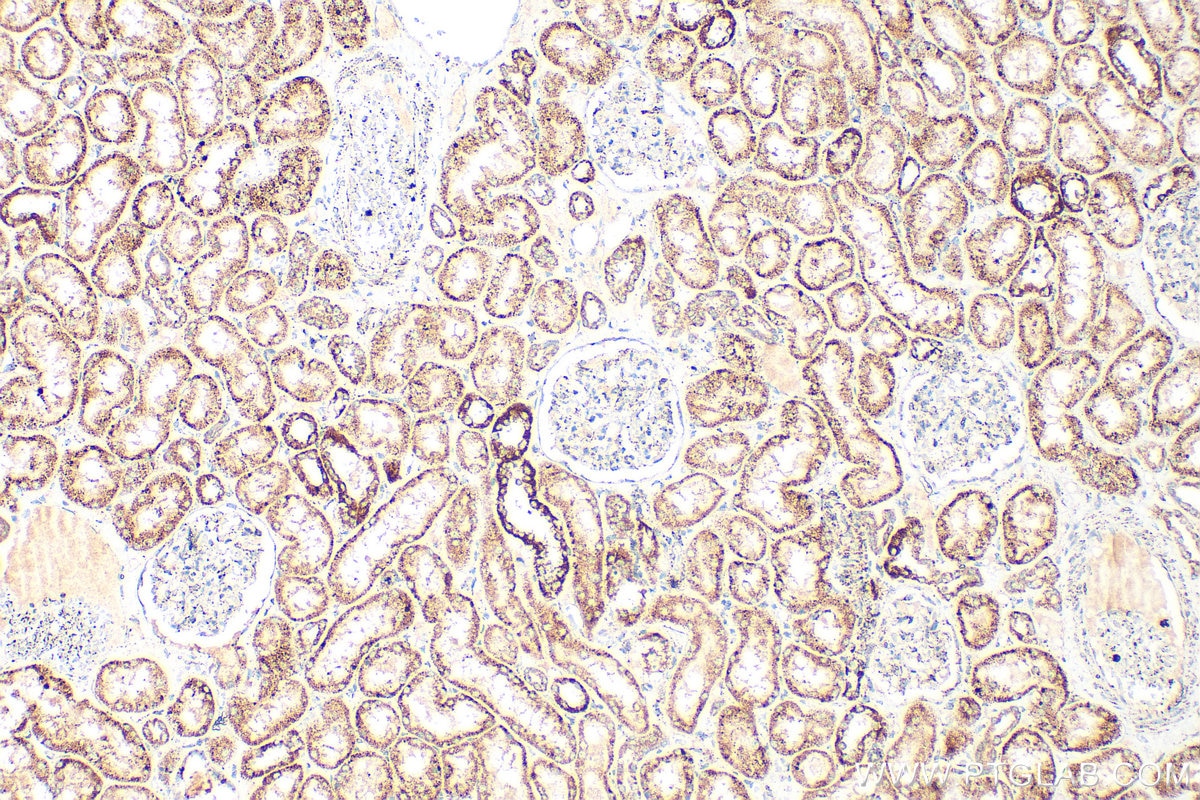
Immunohistochemical analysis of paraffin-embedded human kidney tissue slide using 23996-1-AP (TFAM antibody) at dilution of 1:400 (under 10x lens). Heat mediated antigen retrieval with Tris-EDTA buffer (pH 9.0). Immunohistochemistry (IHC) staining of human kidney tissue using TFAM Polyclonal antibody (23996-1-AP)
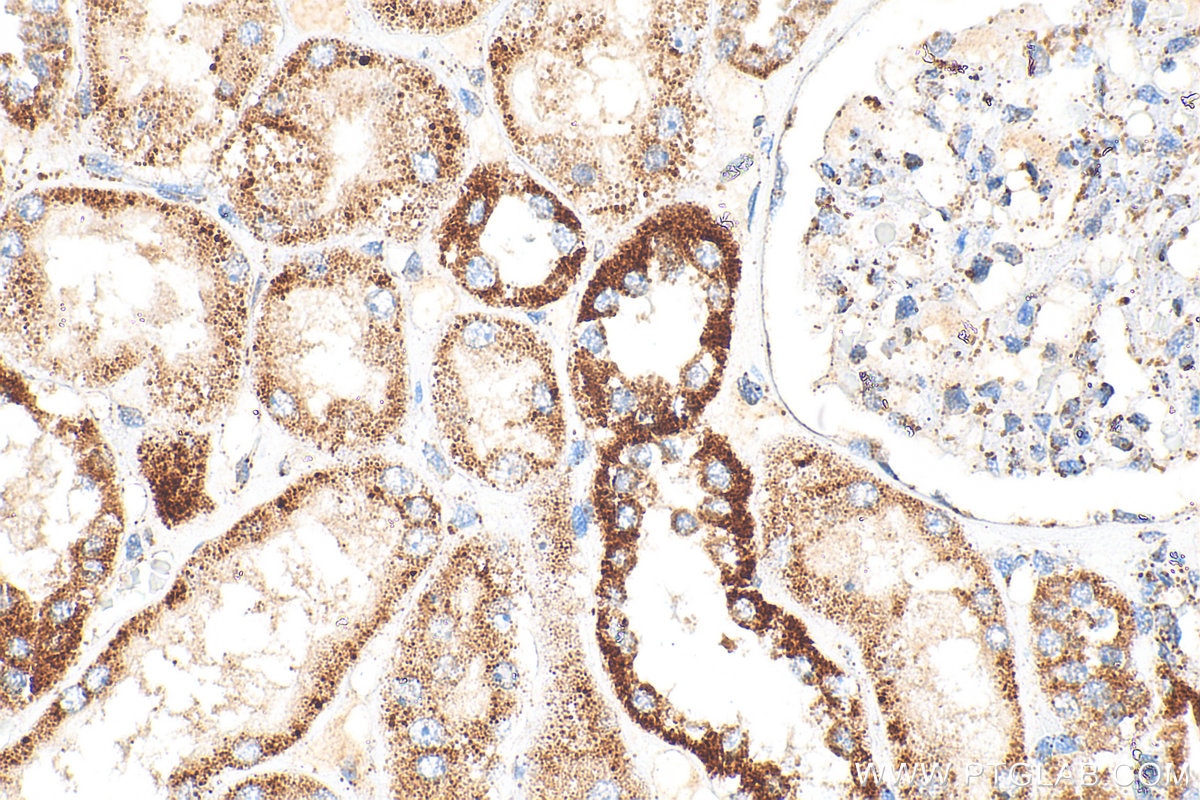
Immunohistochemical analysis of paraffin-embedded human kidney tissue slide using 23996-1-AP (TFAM antibody) at dilution of 1:400 (under 40x lens). Heat mediated antigen retrieval with Tris-EDTA buffer (pH 9.0). Immunohistochemistry (IHC) staining of human kidney tissue using TFAM Polyclonal antibody (23996-1-AP)

Tested Applications
| Positive WB detected in | A431 cells, HEK-293 cells, HL-60 cells, HeLa cells, MCF-7 cells |
| Positive IP detected in | HeLa cells |
| Positive IHC detected in | human kidney tissue Note: suggested antigen retrieval with TE buffer pH 9.0; (*) Alternatively, antigen retrieval may be performed with citrate buffer pH 6.0 |
| Positive IF/ICC detected in | HepG2 cells |
This antibody is only recommended for WB detection of human samples.
Recommended dilution
| Application | Dilution |
|---|---|
| Western Blot (WB) | WB : 1:1000-1:6000 |
| Immunoprecipitation (IP) | IP : 0.5-4.0 ug for 1.0-3.0 mg of total protein lysate |
| Immunohistochemistry (IHC) | IHC : 1:200-1:800 |
| Immunofluorescence (IF)/ICC | IF/ICC : 1:200-1:800 |
| It is recommended that this reagent should be titrated in each testing system to obtain optimal results. | |
| Sample-dependent, Check data in validation data gallery. | |
Published Applications
| WB | See 10 publications below |
| IF | See 3 publications below |
Product Information
23996-1-AP targets TFAM in WB, IHC, IF/ICC, IP, ELISA applications and shows reactivity with human samples.
| Tested Reactivity | human |
| Cited Reactivity | human |
| Host / Isotype | Rabbit / IgG |
| Class | Polyclonal |
| Type | Antibody |
| Immunogen |
CatNo: Ag21196 Product name: Recombinant human TFAM protein Source: e coli.-derived, PGEX-4T Tag: GST Domain: 50-118 aa of BC126366 Sequence: PKKPVSSYLRFSKEQLPIFKAQNPDAKTTELIRRIAQRWRELPDSKKKIYQDAYRAEWQVYKEEISRFK Predict reactive species |
| Full Name | transcription factor A, mitochondrial |
| Calculated Molecular Weight | 246 aa, 29 kDa |
| Observed Molecular Weight | 25 kDa |
| GenBank Accession Number | BC126366 |
| Gene Symbol | TFAM |
| Gene ID (NCBI) | 7019 |
| RRID | AB_2879395 |
| Conjugate | Unconjugated |
| Form | Liquid |
| Purification Method | Antigen Affinity purified |
| UNIPROT ID | Q00059 |
| Storage Buffer | PBS with 0.02% sodium azide and 50% glycerol, pH 7.3. |
| Storage Conditions | Store at -20°C. Stable for one year after shipment. Aliquoting is unnecessary for -20oC storage. 20ul sizes contain 0.1% BSA. |
Background Information
TFAM, also named as TCF6L2, MtTF1, TCF6, TCF6L1, TCF6L3 and mtTFA, is a mitochondrial transcription factor that is a key activator of mitochondrial transcription as well as a participant in mitochondrial genome replication. It is involved in mitochondrial transcription regulation. TFAM is required for accurate and efficient promoter recognition by the mitochondrial RNA polymerase. It activates transcription by binding immediately upstream of transcriptional start sites. TFAM is able to unwind and bend DNA.
Protocols
| Product Specific Protocols | |
|---|---|
| IF protocol for TFAM antibody 23996-1-AP | Download protocol |
| IHC protocol for TFAM antibody 23996-1-AP | Download protocol |
| IP protocol for TFAM antibody 23996-1-AP | Download protocol |
| WB protocol for TFAM antibody 23996-1-AP | Download protocol |
| Standard Protocols | |
|---|---|
| Click here to view our Standard Protocols |
Publications
| Species | Application | Title |
|---|---|---|
Cells Inactivity of Peptidase ClpP Causes Primary Accumulation of Mitochondrial Disaggregase ClpX with Its Interacting Nucleoid Proteins, and of mtDNA. | ||
Biochim Biophys Acta Mol Basis Dis Icariin protects human nucleus pulposus cells from hydrogen peroxide-induced mitochondria-mediated apoptosis by activating nuclear factor erythroid 2-related factor 2. | ||
Cell Death Dis Oxidative stress-induced mitophagy is suppressed by the miR-106b-93-25 cluster in a protective manner. | ||
Cell Death Dis Nitric oxide triggers the assembly of "type II" stress granules linked to decreased cell viability. | ||
Cell Mol Life Sci Melatonin attenuates intervertebral disc degeneration by restoring mitochondrial homeostasis through PGC-1α signaling pathway | ||
J Adv Res Targeting ATM enhances radiation sensitivity of colorectal cancer by Potentiating radiation-induced cell death and antitumor immunity |